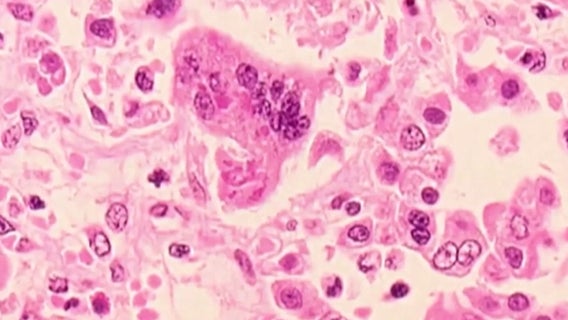
Doctors warn Georgia parents of measles outbreaks across the south

Rob DiRienzo
Rob DiRienzo joined the FOX 5 Atlanta news team in November 2020.
Before coming to Atlanta, he travelled the country covering the 2020 presidential election as a multimedia reporter for the Fox News Channel.
From the moment former Vice President Joe Biden announced his candidacy in Pittsburgh, Pa., through the New Hampshire primaries, all the way to the moment Biden accepted his party's nomination in Wilmington, Del., Rob was there on the ground.
Rob also extensively covered the college admissions scandal in Boston and the legal fallout that followed. At the onset of the coronavirus lockdown, Rob broke the news that tens of thousands of Americans were trapped abroad without a way to get back home. He also put a national spotlight on the eviction crisis and food crisis that intensified because of the pandemic.
Previously, Rob spent his days high above New York City as an airborne reporter aboard WNBC-TV's Chopper 4. He got his start in journalism at the age of 14 at WRNJ-AM, a small radio station in his hometown of Hackettstown, NJ. Later, while studying journalism and political science at Temple University in Philadelphia, he joined FOX 5's sister station FOX 29 as a junior reporter for Good Day Philadelphia.
When he's not at work, Rob loves playing hide-and-seek with his nieces and nephews, long walks through the city, and meeting new dogs in the process. He is obsessed with all kinds of music. Bruce Springsteen, Biggie Smalls, and Miles Davis are some of his all-time favorites.
The latest from Rob DiRienzo
10,000 gallons of jet fuel spills from Hartsfield-Jackson into Flint River
EPA officials say about 10,000 gallons of Jet-A fuel spilled from a faulty fuel pit hydrant Friday.
More student anti-ICE walkouts planned in metro Atlanta despite warnings from school administrators
Protests tied to a recent shooting and the Trump administration’s continued immigration enforcement are spreading to metro Atlanta schools, where students are planning coordinated walkouts.
Legal questions surround FBI search of Fulton election office
Legal scholars are raising questions after FBI agents executed a search warrant at Fulton County’s main election facility, seizing ballots and election records tied to the 2020 presidential election.
Decatur offers housing for foster children transitioning to adulthood
A new transitional living community in Decatur will soon provide housing and support for young adults who aged out of foster care.
'Tactical urbanism' deployed to protect pedestrian lanes in SW Atlanta
Dozens of volunteers installed a protected pedestrian lane as part of a "tactical urbanism" project over the weekend in southwest Atlanta, led by the nonprofit street safety advocacy organization PropelATL.
Doctors warn Georgia parents of measles outbreaks across the south
Georgia health officials are warning parents as measles cases soar in neighboring South Carolina.
Metro Atlanta families 'trapped' in extended stay hotels, new study finds
Thousands of single parents live full-time in extended-stay hotels across metro Atlanta.
Peaceful Atlanta protest targets ICE after Minneapolis killing
Hundreds of protesters marched through downtown Atlanta Thursday night in a peaceful demonstration condemning the killing of a U.S. citizen by an Immigration and Customs Enforcement agent in Minneapolis.
Mother of man fatally shot outside Griffin bar says he was attacked by large group
A 28-year-old man was shot outside a Griffin bar during an altercation in December.
DFACS budget cuts could cause children to 'fall through the cracks'
Georgia's DFACS faces an $85 million budget deficit, leading to deep service cuts for foster families and children with special needs.